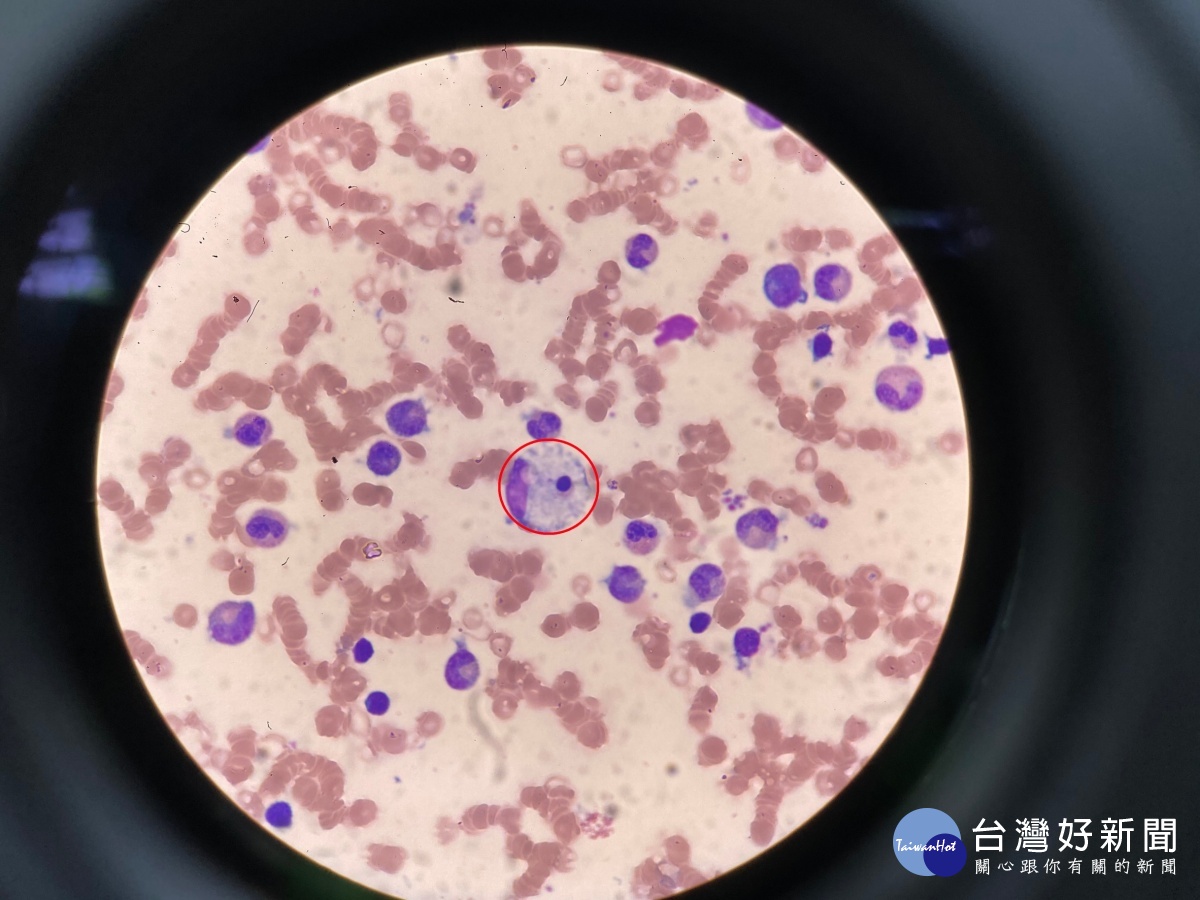

你是幸運得主嗎?動滋券中獎出爐兩樣情 8月起可抵用、抽籤程序複雜引民怨
匯流新聞網記者林欣穎/台北報導
昨(28)日體育署下午直播抽出動滋券得主,直播活動邀請四位國手參與,已射飛鏢的方式選出隨機亂數,再以電腦抽籤程式隨機跑出中獎號碼,所以在活動當下無法得知自己是否得獎,讓許多民眾認為抽獎模式過於複雜。不過從昨天下午到今(29)早上中獎民眾已全數收到簡訊通知,未來兩天可開始領取QR Code,8月起可開放使用。
又有一項振興加碼優惠券抽獎出爐,上次藝FUN券發放僅身分整尾數1、2、6的民眾未中籤,引起「126」民眾怒火,這次動滋券券抽獎疑似為了不要重倒覆轍,特別用現場抽出亂數,並以電腦程式跑抽獎的方式,讓每個身分證號尾樹的民眾都有機會中獎,只是每個尾數的中獎機率不一定,像是中獎率最高的尾數分別為0、8,機率分別是10.43%與10.40%,機率最低的除了本來總數就比較少的尾數4,民眾發現尾數1、2、6再度分別佔據機率最低三名,機率只有10.04%、10.11%與10.10%。
今(29)日早上十點動滋券中獎通知已全數發放完畢,中獎民眾可在明(30)日開始依身分證號碼尾數單雙號分日領取QR Code,尾數雙號者可在30日10點至凌晨十二點領取、單號者31日開放領取,8月起全號可領,也開放在配合店家進行折抵消費。
如果不確定自己是否中獎的民眾,也可以到動滋網網頁上的「中籤查詢」,輸入自己的身分證字號後,就可以得知自己是否中獎。不過,動滋券雖盡量採取較為公平的方式,依然有不少程序引發民怨,像是直播抽籤時無法立刻得知是否中獎,會讓民眾感覺很浪費時間,另外有不少人到凌晨才收到中獎簡訊,抱怨通知太慢,今(29)日起開放網頁查詢,也有民眾發現動滋網網站店家資訊、數量都不明確,網站疑似尚未建設好,讓民眾對要到哪裡花用霧煞煞。
另外,也有部分民眾昨晚間有收到中獎簡訊通知,今(29)日上網查詢後卻顯示未中籤,懷疑是體育署搞烏龍誤發通知,網友們怨聲載道,體育署表示目前正在查明原因為何。也有部分民眾抱怨,自己不僅藝FUN券沒中、動滋券也沒中,直言「自己是不是被國家放棄了?」,不過沒中獎的民眾也不用太灰心,今(29)日又有客遊券800元的抽獎,說不定這次會幸運中獎喔。
新聞照來源:動滋網
【匯流筆陣】
CNEWS歡迎各界投書,來稿請寄至[email protected],並請附上真實姓名、聯絡方式與職業身份簡介。
CNEWS匯流新聞網:https://cnews.com.tw
【文章轉載請註明出處 】